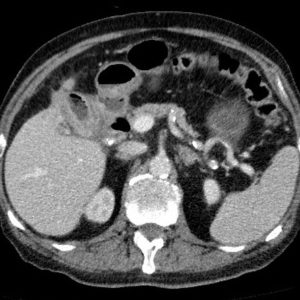
Tắc ruột sỏi mật

TIÊU HOÁ
Hiển thị 1141–1160 của 1445 kết quảĐã sắp xếp theo mới nhất
-

U giả nhầy phúc mạc
Lượt xem: 502» 27-11-2018 -

U tá tràng
Lượt xem: 528» 27-11-2018 -

Nhồi máu ruột
Lượt xem: 494» 27-11-2018 -

Nang sán chó
Lượt xem: 446» 26-11-2018 -

Xoắn manh tràng
Lượt xem: 895» 26-11-2018 -

Túi thừa đại tràng
Lượt xem: 462» 26-11-2018 -

U nhầy ruột thừa
Lượt xem: 601» 26-11-2018 -

Lồng ruột
Lượt xem: 467» 25-11-2018 -

Ung thư túi mật
Lượt xem: 426» 25-11-2018 -

Tắc ruột sỏi mật
Lượt xem: 469» 25-11-2018 -

Lồng ruột
Lượt xem: 515» 25-11-2018 -

Lồng ruột
Lượt xem: 230» 25-11-2018 -

Viêm tụy mạn
Lượt xem: 315» 24-11-2018 -

Bùn túi mật
Lượt xem: 218» 24-11-2018 -

Thủng tạng rỗng
Lượt xem: 248» 24-11-2018 -

Biloma
Lượt xem: 232» 24-11-2018 -

Lồng ruột
Lượt xem: 203» 24-11-2018 -

Dị vật ổ bụng
Lượt xem: 262» 23-11-2018 -

Thoát vị hoành
Lượt xem: 198» 22-11-2018 -

Nhồi máu mạc nối
Lượt xem: 186» 22-11-2018